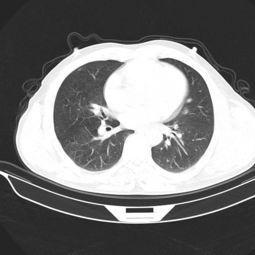

你有没有想过,有时候身体的小秘密,就像藏宝图一样,需要我们用心去探索呢?今天,我就要带你揭开一个神秘的面纱——淋巴结触诊。没错,就是那个你可能只在医生口中听过的名词。别急,别急,我这就给你带来一场视觉盛宴,让你通过淋巴结触诊视频,一探究竟!
一、淋巴结:身体的“哨兵”

你知道吗?淋巴结就像是人体内的“哨兵”,它们分布在全身各个部位,默默地守护着我们的健康。当细菌、病毒或者其他有害物质入侵时,淋巴结就会“站出来”进行战斗。所以,了解淋巴结,就是了解我们身体的免疫系统。
二、淋巴结触诊:一种自我检查的方法

那么,如何检查淋巴结是否健康呢?这时候,淋巴结触诊就派上用场了。其实,淋巴结触诊并不复杂,只要掌握一些技巧,你就可以在家里进行自我检查。
三、淋巴结触诊视频:你的私人医生
说到淋巴结触诊,不得不提的就是淋巴结触诊视频。这些视频就像是一位贴心的私人医生,手把手地教你如何进行淋巴结触诊。不信?那就跟我一起看看吧!
四、淋巴结触诊视频:操作步骤详解
1. 选择合适的时间:最好在洗澡后进行,这时候皮肤比较松弛,更容易触摸到淋巴结。
2. 选择合适的部位:淋巴结分布在全身各个部位,常见的有颈部、腋下、腹股沟等。
3. 观察淋巴结的大小和形状:正常的淋巴结应该是柔软、光滑、无压痛的。如果发现淋巴结肿大、坚硬或有压痛,那就需要引起重视了。
4. 视频学习:淋巴结触诊视频会详细展示每个部位的触诊方法,你可以跟着视频一步步学习。
五、淋巴结触诊视频:案例分析
下面,我就以一个淋巴结触诊视频为例,带你看看如何进行淋巴结触诊。
案例:这是一段关于颈部淋巴结触诊的视频。
1. 视频开始,医生首先介绍了颈部淋巴结的位置和功能。
2. 接着,医生展示了如何用手指轻轻触摸颈部淋巴结,观察其大小、形状和是否有压痛。
3. 视频中还穿插了一些实际案例,让观众更直观地了解淋巴结触诊的重要性。
4. 医生还提醒观众,如果发现淋巴结异常,应及时就医。
通过这段视频,我们可以清楚地了解到颈部淋巴结触诊的方法和注意事项。
淋巴结触诊视频是一种非常实用的自我检查方法。通过观看这些视频,我们可以学会如何进行淋巴结触诊,及时发现身体的小秘密。当然,如果你有任何疑问,还是建议咨询专业的医生。毕竟,健康才是最重要的!






